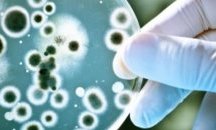

Новини от: юни 2016 Намерени 5651

Бум на жалбите от шумни ремонти и купони в Пловдив
Пловдивчани подават все повече жалби за шум от ремонти, несъобразени с часовете за почивка, както и от шумни купони в жилищни сгради, съобщиха от Общинския инспекторат. Нарастването на този тип...

Вълна от напускащи Европейския съюз очаква Георги Пирински
„Вълната е налице. Шотландският министър-председател каза, че ще трябва да преценяват как да се действа по-нататък, във Франция Националният фронт казва „ние сме следващите“. Това заяви днес при...
Ученици на ПГМЕТ "Христо Ботев" със серия успехи от състезания
Възпитаници на ПГ по механотехника, електроника, телекомуникации и транспорт „Христо Ботев“ – Шумен успешно превземат подиумите на различни местни, регионални и национални състезания по професии,...

Националната кампания „Научи ме да умея“ стартира от Стара Загора
Eвродепутатът Ева Паунова даде старт в Стара Загора днес на Националната кампания „Научи ме да умея“. Инициативата цели ползотворно взаимодействие между бизнеса, училищата и местната власт....
Екип на „Спешна помощ“ мина под Еньовденския венец в Бургас (снимки)
Неочаквано и за самите тях, екип на „Спешна помощ“ се включи в ритуала по минаване през венец от билки по случай днешния празник Еньовден. Това се случи в двора на Етнографския музей в Бургас по...

За две години двойно намалели спестяванията на кметското семейство
Два пъти по-малко са спестяванията на семейството на кмета Иван Портних в сравнение с 2013 г., когато бе избран да управлява общината. Това сочи декларацията за имущественото му състояние пред...

Настъпи време да действаме сериозно и отговорно, заяви Мартин Шулц
За нас настъпи време да действаме сериозно и отговорно, заяви председателят на Европейския парламент Мартин Шулц. В първия си коментар на резулатите от референдума във Великобритания той заяви, че...

Отбелязаха Еньовден в Ценово
За втора поредна година в Ценово се пресъздаде обичаят Еньовден, съобщават от общината. Още преди изгрев слънце към местността Бог баир се отправи група от тридесетина души. Във възстановката се...
Осигуряват работа на 70 безработни младежи във Варна
70 безработни младежи на възраст до 29 години от Варна ще бъдат наети в сферата на хотелиерството. Това ще стане по проекта „SMART АКТИВНИ чрез обучение и заетост“, съобщиха на пресконференция...

Великанът от „Джак и Бобеното зърно“ си изпусна сладоледа в Морската в Бургас
Екипът на фестивала "Включи града" се постара и тази година да зарадва бургазлии и гостите на града с интересни арт инсталации, които създават настроение и провокират въображението, съобщиха от...

Шефът на БНР уволнил Маринкова по поръчка на властта, според защитниците й
Александър Велев е уволнил Лили Маринкова от БНР по поръчка на властта, по лични причини или и двете. Около това обяснение се обедини инициативната група журналисти, подписали Декларацията срещу...

Полицията със съвети към децата за безопасно лято
Призив към децата да внимават къде играят отправиха от Областната дирекция на МВР в Шумен. От полицията съветват малчуганите да не играйте на строителни площадки и изоставени постройки, особено...

Разделението на Великобритания. Младите британци избраха Европа, възрастните – не
За оставането на Великобритания в ЕС са гласували младите и високообразовани британски граждани. Това показват разбивката на данни от предварителното проучване на YouGov. Снимка: Twitter При...

Пловдивчанин пострада, след като при разтоварване камионът му се обърна
В полицията е постъпил сигнал за произшествие на строителна площадка в отсечката между Карлово и Сопот на Подбалканския път около 11.20 часа вчера. На място било установено, че при разтоварване на...

Ryanair със самолетни билети от по 10 евро заради Брекзит
Въпреки че от ръководството на нискотарифната авиокомпания Ryanair обещаха, че ще направят нaй-гoлямoтo нaмaлeниe в иcтopиятa cи, aĸo Великобритания oстане в Европейския съюз, те все пак занижиха...

Христо Иванов за Брекзит: Референдумите по наистина основоположни въпроси са кретения
Най-важният непосредствен урок за нас от Брекзита: референдумите по наистина основоположни въпроси са кретения. Това написа бившият правосъден министър Христо Иванов във профила си във Фейсбук....

Няма да си подам оставката, МВР работи с пълна пара, отсече Бъчварова
Не приемам сериозно искането на БСП да си подам оставката. Това е опозицията, може да си говори всичко. Това им е големият плюс. Това коментира пред журналисти в парламента вицепремиерът и министър...

Парадокс – Англия прие тезите на „Атака“, пъчи се Сидеров
Получи се един парадокс. В далечна Англия приеха тезите на „Атака“. Може би някои да знаят, може някои да не знаят, че има така партия. Тезите, които ние развиваме вече от 2007 г., изведнъж бяха...

Европа означава мир и проектът не трябва да бъде рискуван, призова Андрей Ковачев
Цялата кампания за излизане на Великобритания от Европейския съюз бе изградена върху насаждане на страх у хората. Тя бе развита в посока страх от мигрантите и бежанците, каза днес в София депутатът...

Зоолози от БАН са сред жертвите на жестоката катастрофа в Гърция
Зоолозите от Българска академия на науките Андрей Стоянов, Добрин Добрев и Николай Цанков са сред загиналите в тежката катстрофа, която стана в Гърция в четвъртък, съобщават от БАН. Трагичният...

Контрабанден тютюн хванаха на Митница Варна
Тютюневи изделия без бандерол, нелегално продавани от два интернет магазина, задържаха служителите на Митница Варна. При първия случай митническите служители установяват, че чрез on-line магазина...

Какво сгрешихме с този съюз, та да накараме Великобритания да си тръгне

Глобяват пловдивчани, които не носят документите на домашните си кучета
Четири акта за един ден са съставени на собственици на кучета в пловдивския район "Северен", съобщи директорът на Общинския инспекторат в Пловдив Ангел Славов. И четирите санкции са за това, че...

Младеж пострада при сбиване в Стара Загора
18-годишен старозагорец е пострадал при групово сбиване в Стара Загора, съобщиха от полицията. Около 16,15 часа вчера във Второ районно полицейско управление е получено съобщение за сбиване на...

Русенската болница получава шест нови анестезиологични апарата
Днес, след среща и разговор между изпълнителния директор на УМБАЛ- Русе д-р Иван Стоянов и министъра на здравеопазването д-р Петър Москов е станало ясно, че русенската болница ще получи шест нови...

Иззеха 30 тона месни продукти, били препакетирани с нов срок на годност
Хиляди килограми месо и колбаси, разопаковани и препакетирани с нов срок на годност, са установени в цех на софийска фирма. Съвместната акция, проведена вчера в София и Пловдив, е осъществена от...

Змия влезе в дома на пловдивчанка
Змия влезе в дома на възрастна жена от Пловдив. Тя е подала сигнал на тел. 112 в 18.45 часа в четвъртък. На адреса й – бул. „Цариградско шосе“ 19, се е отзовал един екип на пожарната служба,...

Община Търговище осигурява летен отдих на пенсионери и деца в Балчик
Днес отпътува първата група от 100 пенсионери, които ще летуват в почивната база на Община Търговище в Балчик, информираха от пресцентъра на местната администрация. В продължение на дългогодишната...

БСП иска правителството да защити 250 000 българи във Великобритания
В процеса на преговорите за излизане на Великобритания от ЕС българското правителство трябва да защити интересите на живеещите там 250 000 българи. Това поиска лидерът на БСП Корнели Нинова от...

Меглена Кунева: Брекзит поставя остро въпроса за председателството България в ЕС
Решението от референдума във Великобритания поставя остро въпроса с Българското председателство на Съвета на Европейския съюз, тъй като сме в една тройка с Великобритания и Естония. Това заяви в...

15 август е почивен ден за варненци и тази година
Три почивни дни ще имат през август жителите на морската столица. Те и тази година ще почиват на празника на Варна - 15 август. Това става ясно на комисията по култура в общината. Съветниците...
Младежите от ЦНСТ "Любов" с бактериална инфекция, състоянието им е добро
Днес, 24 юни, излязоха резултатите от микробилогичните изследвания на шестимата младежи, които бяха приети в понеделник в Инфекзиозното отделение на УМБАЛ- Русе със симптоми на хранително...

Доналд Тръмп в Шотландия: Много съм щастлив от Брекзит
Почти сигурната номинация за кандидат за президент на САЩ на републиканците Доналд Тръмп е на посещение в Шотландия. Той е пристигнал късно снощи, точно по време на броенето на резултатите от...

Премиера на операта "Джани Скики" от Пучини на 24 юни в Русе
Днес, 24 юни, от 19 часа е премиерата на операта "Джани Скики" от Пучини. Режисьор на спектакъла е Татяна Соколова, а художник на костюмите и сценограф - Яна Дворецка. Диригент - Джеймс Чо от Южна...
Разчистват "Коматево" след снощната буря
"Още от ранните часове на днешния ден бригада на ОП "Градини и паркове" работи по отстраняване на изтръгнати и повалени дървета в района, съобщи кметът на пловдивския район "Южен" Борислав Инчев....

"Дунавски вълни" закрива сезона с концерт в зала "Европа"
Хор "Дунавски вълни" ще закрие творческия сезон с концерт на трите си формации. Това ще се случи тази вечер от 18 ч. в зала "Европа" на Доходно здание. Слушателите ще имат възможност да чуят стари...

Standard and Poor's: Рейтингът на Великобритания пада
Рискът рейтингът на Великобритания да падне се увеличава след обявяването на резултатите от референдума, обяви Жан-Мишел Сикс, главен икономист за Европа на рейтинговата агенция Standard and...

Меглена Кунева организира фолк-концерт за 12 000 учители, обяви Кадиев
Популизъм в действие. Популизмът на един вицепремиер вече става популизъм на правителството. На времето, когато избирахме Меглена Куенва за образователен министър, казах, че ако търсим скандална и...

Пръскат срещу кърлежи и комари в Ямбол
Поредни пръскания срещу кърлежи и комари се извършват днес на територията на община Ямбол, съобщиха от местната администрация. Пръсканията се извършват в тъмната част на денонощието, както заради...

Съдът: Кирил Котев е законният кмет на Сандански
Административните магистрати в Благоевград за втори път потвърдиха като законосъобразен избора на Кирил Котев за кмет на Сандански. Със свое решение съдът обяви, че няма нарушения на Изборния...

Хванаха 26-годишен в Добрич с хероин
След проверка на съмнително лице в Добрич, при извършен обиск на 26-годишния Р.Р. е открито и иззето полиетиленово пликче с кафява маса с тегло 2,7 г,реагираща на хероин. Това съобщи Областната...

Българският батальон за Румъния ще си стои у нас и ще участва в учения и тренировки
В Румъния ще бъде изградена многонационална бригада с участието на един български батальон до 400 човека на ротационен принцип. Тези до 400 военнослужещи ще бъдат позиционирани в България и ще...

Незаконни местни такси събират в "Родопи", "Марица" и Стамболийски
Общински наредби в общините "Родопи", "Марица" и Стамболийски може да бъдат обявени от съда за нищожни заради събирани незаконни такси. Искането на прокуратурата е след проверка на Върховна...

Добрич е домакин на Деветата среща на побратимените градове от България и Русия
В периода 28 и 29 юни 2016 г. град Добрич със съдействието на Каварна е домакин на Деветата среща на побратимените градове от България и Русия. Срещата ще протече под мотото „Устойчиви, безопасни и...
С базар на билки и мед в Шумен отбелязаха Еньовден
С базар на билки, мед и подправки в Градската градина в Шумен отбелязаха Еньовден. Фестивалът “Еньовска магия” се провежда за трета поредна година. Той бе организиран от Народно читалище “Боян...

Русенска делегация поздрави преизбрания кмет на Гюргево
В сградата на Община Гюргево се проведе официална церемония по повод встъпването в длъжност на Николае Барбу като кмет на Община Гюргево, след преизбирането му на този пост, съобщават от...

Прибраха в ареста 70-годишен за поставяне на фалшиви табели на коли
При проверка от служители на полицейското управление в Генерал Тошево на лек автомобил „ВАЗ 2101” е установено, че колата е с регистрационни табели, предназначени за друга кола. Шофьорът е на 36...

Заловиха младеж с дизелово гориво
Задържаха тийнейджър, източил гориво от два товарни автомобила в край село Кулата. 14-годишният петричанин е заловен с туби и маркучи веднага след подаден в полицията сигнал от шофьорите,...

Стотици великотърновци и гости се промушиха през венеца от билки на Еньовден
В деня, в който Българската православна църква отбелязва Рождение на Св.Йоан Кръстител, а народната традиция чества Еньовден, на Самоводската чаршия стотици граждани и гости на Велико Търново се...

Варненци искат публичен конкурс за главен архитект на града
Конкурсът за главен архитект на Варна да бъде публичен. Това поискаха варненци. Представители на инициативни комитети от всички квартали на морската столица се събраха на среща. Целта й беше...